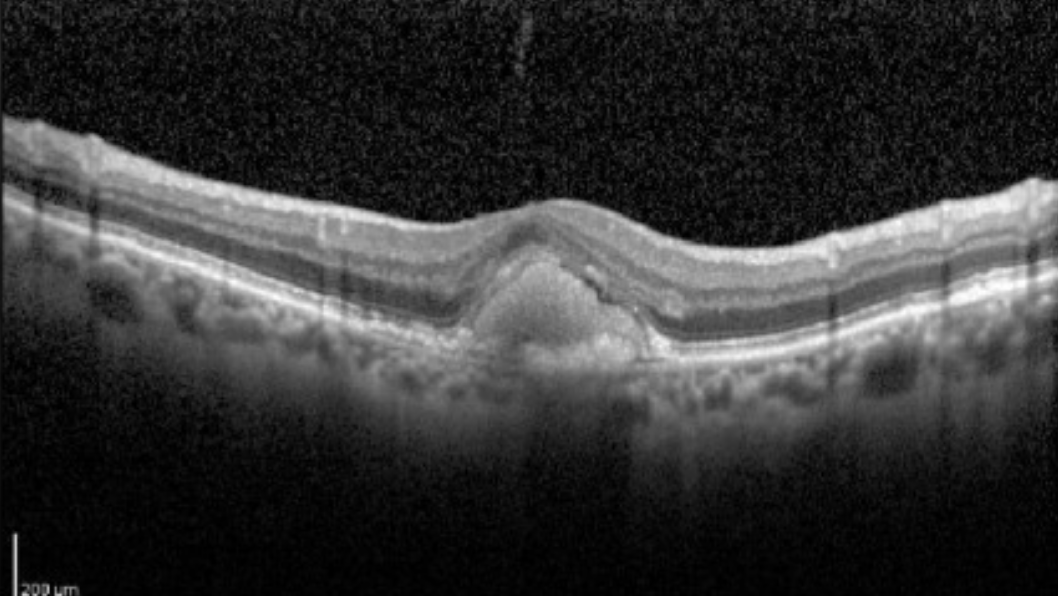

Chief Complaint: I have distorted vision
Demographic
Age: 35
Biological sex: Male
Race: White
Ethnicity: Not Hispanic or Latino
Medications
None
Before you continue, what questions do you want to ask this patient?

ROS
Constitutional: Denies
Genitourinary: Denies
ENT: Denies
Musculoskeletal: Denies
Cardiovascular: Denies
Neurologic: Denies
Pulmonary: Denies
Psychiatric: Denies
Endocrine: Denies
Immunologic: Denies
Dermatological: Denies
Hematologic: Denies
Gastrointestinal: Denies
Obstetrical: Denies



Rocha Bastos R, Ferreira CS, Brandão E, Falcão-Reis F, Carneiro ÂM. Multimodal Image Analysis in Acquired Vitelliform Lesions and Adult-Onset Foveomacular Vitelliform Dystrophy. J Ophthalmol. 2016;2016:6037537. doi:10.1155/2016/6037537 (image cropped)
-
Fluorescein Angiography to rule out leakage
OCT macula to rule out macular involvement
Genetic testing to rule out inherited retinal disease
EOG to rule out Best disease
Format: [Testing] [Reason]
Example: Fundus photos to rule out retinal disease

Rocha Bastos R, Ferreira CS, Brandão E, Falcão-Reis F, Carneiro ÂM. Multimodal Image Analysis in Acquired Vitelliform Lesions and Adult-Onset Foveomacular Vitelliform Dystrophy. J Ophthalmol. 2016;2016:6037537. doi:10.1155/2016/6037537 (image cropped)
Rocha Bastos R, Ferreira CS, Brandão E, Falcão-Reis F, Carneiro ÂM. Multimodal Image Analysis in Acquired Vitelliform Lesions and Adult-Onset Foveomacular Vitelliform Dystrophy. J Ophthalmol. 2016;2016:6037537. doi:10.1155/2016/6037537 (image cropped)
Genetic testing: BEST1 mutation
Arden Ratio: 1.50
-
Adult Foveomacular Vitelliform Retinal Dystrophy, OU
-
Educated patient on findings. Referred to retina specialist for evaluation, monitoring, and consideration of anti-VEGF intravitreal injections if choroidal neovascular membrane (CNVM) develops. Instructed patient to monitor vision at home with an Amsler grid and report any new distortion, blurring, or scotomas immediately. Return to clinic in 3 months for continued monitoring with dilated fundus examination and OCT imaging.
-
Educated the patient on the diagnosis of Adult Foveomacular Vitelliform Retinal Dystrophy, explaining that it is a degenerative macular condition characterized by gradual buildup of material under the retina, which may lead to progressive central vision loss. Reviewed that while the disease typically progresses slowly, complications such as CNVM can cause more rapid vision deterioration and may require treatment injections. Reinforced that there are currently no therapies to reverse the underlying condition, but treatment of complications can help preserve vision.